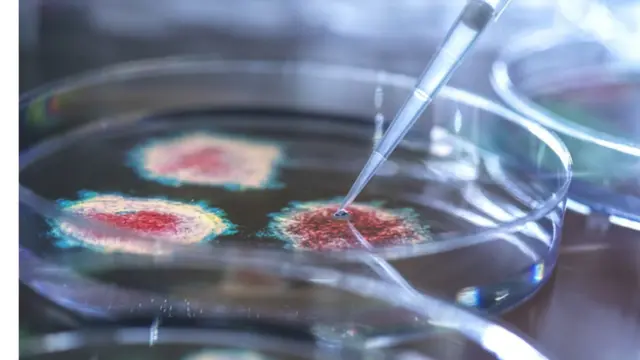
virus

Coronavirus: "No hemos entendido nada del virus, pero eso no es desalentador"

Fuente de la imagen, Puerto de Ideas
- Autor, Carlos Serrano (@carliserrano)
- Título del autor, BBC News Mundo
- Tiempo de lectura: 11 min
En esta pandemia, la esperanza ha estado puesta en las soluciones que pueda ofrecer la ciencia para combatir el virus y poner fin a la crisis global.
Pero, ¿qué pasa cuando la ciencia tampoco tiene todas las respuestas?
Entre los ciudadanos, es común que esa incertidumbre cause miedo y ansiedad, y en algunos casos deriva en la desconfianza hacia la ciencia.
Los científicos, sin embargo, están acostumbrados a lidiar con esa incertidumbre. De hecho, es parte de su trabajo.
Sobre ese manejo de la incertdumbre conversamos con la inmunóloga y bióloga celular Ana María Lennon, quien a mediados de abril participó en una charla titulada "No lo sé: la ciencia y la dificultad de comunicar incertezas", en el festival Puerto de Ideas, de Antofagasta, Chile.
Lennon habla sobre cómo la pandemia le genera reflexiones sobre el rol de los científicos en la sociedad, los retos de comunicar lo que no se sabe sobre el coronavirus y la necesidad de que en la sociedad haya un mayor conocimiento del método científico y se estimule el pensamiento crítico.

Fuente de la imagen, Getty
Licenciada de Biología en la Universidad de Chile, Lennon obtuvo una maestría y un doctorado en genética por el Instituto Pasteur (Francia) y realizó estudios postdoctorales en la Universidad de Harvard (EE.UU). Ha desarrollado gran parte de su carrera en Francia, en el Instituto Curie, uno de los más importantes del campo de la medicina y la biología a nivel mundial.
Su carrera científica se ha enfocado en el funcionamiento de las células en el sistema inmunológico.
En 2018 fue reconocida con el Premio Nacional de Investigación, otorgado por el Instituto Nacional de Investigación en Salud y Medicina de Francia.
Lo que sigue, es una resumen editado de la conversación con la científica Ana María Lennon.

En esta pandemia todos nos hemos enfrentado a la incertidumbre, pero entiendo que para ustedes los científicos eso es algo cotidiano...
Claro, eso es un punto esencial. Es que en el fondo la sociedad ha estado expuesta a lo que nosotros vivimos cada día, que es tratar de entender lo que no se entiende y, claro, al estar expuesta a eso, la gente ha tenido que tomar conciencia de lo poco que se sabía, y de lo humildes que nosotros los científicos tenemos que ser, porque queda mucho por descubrir.
La naturaleza nos vive sorprendiendo y eso pienso que genera mucho estrés, porque en el fondo la sociedad no entiende bien lo que es el proceso científico, de hacer una pregunta científica, de diseñar un experimento, de interpretar el resultado de ese experimento para tratar de contestar esa pregunta, y, a partir de eso, ir construyendo conocimiento, construyendo teoría de manera colectiva con los otros colegas científicos.
Ese proceso era desconocido hasta ahora de la sociedad y ahora lo están empezando a entender.
Al desconocer ese proceso, ver que los científicos dicen un día algo basado sobre los primeros experimentos que diseñaron y que interpretaron, y luego van a decir otra cosa porque agregaron un experimento nuevo, y que en realidad eso aporta un elemento de interpretación que cambia, porque cada interpretación está muy sujeta limitada al marco de cada experimento, eso ha sido mucho estrés, yo creo que para todo el mundo.
Creo que los periodistas también han sido los mediadores de ese estrés, porque muchas veces se han empoderado de las malas noticias, más que las buenas, porque no sé, quizás se vendan más, y las han deformado simplemente porque las han sacado de su contexto científico, del marco del experimento y así algo puede estar siendo interpretado de una manera totalmente distinta.

Fuente de la imagen, Getty
Algo que ha pasado en la pandemia es que, sobre todo en las redes sociales, de un momento a otro mucha gente comenzó a opinar como expertos en virus. ¿Cómo ha visto usted ese fenómeno?
Para nosotros es gracioso porque somos todo lo contrario. A nosotros los científicos nos cuesta mucho hablar de algo antes de entenderlo en profundidad.
Yo, por ejemplo, no me atrevería considerarme experta en virus. No soy viróloga, soy inmunóloga y bióloga celular. Me considero experta en células dendríticas, en macrófagos, en migración celular, pero no me considero experta en absoluto en virus.
Entonces, sí me hace mucha gracia que gente que ni siquiera es científica se pueda considerar experta.
Me parece que hay un desconocimiento profundo de lo que es la ciencia y el proceso científico por parte de la sociedad, y eso es lo que la pandemia nos ha revelado.
Me parece que nuestra misión en adelante, y también la misión de los profesores y de todos los que van a definir la educación científica en una sociedad, es hacer entender ese proceso.
No solo transmitir conocimiento científico, conocimiento que de hecho se puede encontrar en internet. El conocimiento per se hoy está muy disponible, pero cómo se ha llegado a ese conocimiento y cuál es el método científico, la manera de pensar que se ha utilizado para poder generar ese conocimiento, eso es lo que debemos explicar mejor, y eso es en parte por nuestra culpa, porque hemos estado muy aislados, no nos hemos implicado suficientemente dentro de la sociedad.
Yo creo que ese pensamiento crítico que surge del método científico, que es un pensamiento analítico, reflexivo y más riguroso que el pensamiento común, puede ser muy útil en la sociedad, más allá de la ciencia.

Fuente de la imagen, Getty
¿Para usted la pandemia ha sido una señal de que los científicos deben abrirse a más a la sociedad?
A mí me lo está diciendo, sin duda. Debo abrirme más, pero también los políticos, los profesores, etcétera, deben también estar más dispuestos a recibir el conocimiento científico.
Lo otro que me ha revelado es que los periodistas tengan también una formación científica, que ellos mismos hayan experimentado lo que es la investigación en laboratorio.
Entre los estudiantes de doctorado, por ejemplo, sé que muchos de ellos no van a seguir una carrera en investigación y muchos de ellos me los podría imaginar como periodistas.
Creo que hay que generar esa pasarela para permitirle a estudiantes que han hecho ciencia, que han hecho doctorado, volverse mediadores hacia la sociedad, por ejemplo en la forma de periodismo, pero también en la forma de profesores, de gente implicada más en la política, en la organización de la educación, etcétera.

Fuente de la imagen, Getty
Una frase que hemos escuchado mucho por parte de los políticos durante la pandemia es "estamos haciendo lo que nos dice la ciencia". Algunos expertos, sin embargo, advierten que hay riesgos en el uso de esa expresión. ¿Usted qué opina?
Yo pienso que es incorreto, profundamente incorrecto. Pienso que muchos políticos se han escondido detrás de eso para evitar que se les considere responsables de la situación, y eso está mal.
A mi me parece que lo correcto es decir que los políticos están escuchando a los científicos, lo que es verdad, pero que después ellos toman las decisiones basados en lo que dicen los científicos, pero también en todo el resto, los intereses económicos, en las consecuencias psicológicas que puede haber sobre la gente, etcétera.
Eso es lo correcto cuando uno es político. Yo encontraría absurdo que solo se fijaran en la ciencia. Tienen que tomarla en cuenta, pero la ciencia no va a aportar todas las soluciones.
De hecho, en esta pandemia por el momento no se ha encontrado una solución absoluta. Espero que se encuentre luego en las vacunas, y esa sí ha sido una labor de la ciencia.
Creo que antes de criticar a los científicos porque dijeron una cosa y luego otra, sobre todo se ha de valorar que fue la ciencia, a través de las vacunas, la que nos va a permitir acortar este proceso que ya está siendo muy largo.
¿Cree que al gremio científico le cabe algo de responsabilidad política por el uso que se haga de los datos que ofrecen?
Lo que me ha preocupado mucho es la deformación de lo que uno dice, sacándolo de contexto. Ese es todo el problema.
La conclusión de un experimento depende del marco del experimento y al sacarlo de ese contexto, y eso hacen los periodistas, falsean las conclusiones. Por lo tanto, transmite a la sociedad un mensaje que en muchos casos es falso.
La ciencia no se puede resumir en una frase de cinco, seis palabras. El resultado científico es algo que se solo se puede resumir en el contexto del experimento que se realizó.

Fuente de la imagen, Getty
Durante la pandemia ha habido mucha incertidumbre, pero, paradojicamente, cuando los laboratorios comenzaron a mostrar que las vacunas sí funcionan, una parte de la sociedad fue escéptica ante esta solución. ¿Qué reflexión le genera eso?
Eso me entristece. De nuevo, es un desconocimiento profundo de lo que es el proceso de hacer vacunas.
Es cierto que el coronavirus no se había descrito hasta el año pasado, pero también es cierto que desde hace casi un siglo se vienen fabricando vacunas. Los científicos saben hacer vacunas.
Dos de las vacunas que están funcionando muy bien son de ARNm, que son muy novedosas. Son vacunas que ya se habían hecho en el contexto de cáncer. No habían sido eficientes curando el cáncer, pero sí se habían estudiado desde el punto de vista de la seguridad.
Así que la tecnolgía ya estaba ahí, y el riesgo ya había sido en gran parte evaluado.
Respecto a las otras, como la Sinovac, AstraZenca o Johnson & Johnson, esas son vacunas más clásicas.
Sinovac, por ejemplo, tiene un virus atenuado. Eso representa cero riesgos, excepto un poco de fiebre y sentirse mal un par de horas.
Las otras vacunas que utilizan vectores virales, adenovirus, esos son vectores muy clásicos que se usan en muchas otras vacunas. Entonces, si la gente se vacuna contra la gripe que utiliza ese mismo tipo de vector, ¿por qué no se quiere vacunar contra el coronavirus? Eso es absurdo. Es totalmente absurdo.
Me impacta el hecho de que esto ha sido un golpe y que la gente está aburrida. Yo personalmente, estoy muy cansada del aislamiento, estoy muy cansada de no poder viajar a ver a mi familia, de restringirme en mis desplazamientos, en mi interacciones sociales, etcétera, y quiero volver a la normalidad, y pienso que la única manera de volver a la normalidad lo más rápido posible es que todo el mundo se vacune.
Pero también es cierto que por más que la ciencia nos de datos racionales, los humanos no somos totalmente racionales, y puede haber otros factores que nos hagan dudar o asumir comportamientos de riesgo...
La ciencia dice que al tener un mejor entendimiento del método científico y de la generación del pensamiento crítico y analítico, uno se va a volver un ser más racional y va a dejar de tomar decisiones absurdas.

Fuente de la imagen, Getty
¿Le preocupa que la incertidumbre que hay, por ejemplo, respecto al origen extacto del virus o a los casos aislados de trombosis que han ocurrido, alimenten la desconfianza en la ciencia?
Déjame distinguir entre esos dos ejemplos.
Lo de las trombosis es algo muy reciente. No dudo de que la gente que trabaja en la fabricación de vacunas está pensando en los estudios para entender si estos casos de trombosis están asociados a las vacunas y si es así, por qué ocurren.
Hay que entender que el proceso científico es lento. Uno no se acostumbra nunca. Yo cada vez que me doy cuenta de que tres meses más tarde todavía no tenemos la respuesta a tal pregunta que nos hicimos, pienso "que lento esto", y sí, es lento.
Por eso también encuentro insólito que hayan logrado fabricar las vacunas tan rápido, porque hay un contraste muy grande entre la eficencia que hubo ahí, que en el fondo refleja muchos años de experiencia de esos profesionales haciendo vacunas, y la lentitud global en el proceso científico, de generación de conocimiento.
Entonces hay que distinguir, porque el otro ejemplo es el del origen del virus.
Eso es más complicado, porque todavía no se ha entendido el origen del virus, y ahí es legítimo preguntarse si todas las informaciones han estado disponibles para evaluar si este virus puede haber encontrado su origen en un laboratorio.
La verdad es que esa posibilidad no se puede excluir. Nada dice que así es, pero nada dice que así no es.
Mientras tanto, lo que se entiende es que el virus más cercano del coronavirus que nos está atacando desde hace un año es un virus del murciélago, que es 96% homólogo al virus que nos infecta hoy.
Ese 96% de homología no es suficiente para explicar una zoonosis directa, es decir, un paso directo del murciélago al ser humano. Entonces, ahí se busca un animal intermedio, que se había sugerido que podía ser el pangolín, pero claramente no lo es.
Entonces, mientras no se haya encontrado ese animal intermedio, no se puede decir si esa es la hipótesis correcta.
Después está el problema de la ubicación del virus en China. La epidemia comenzo en Wuhan, y este virus de murciélago está en Yunnan, a más de 1.000 km de Wuhan.
Los equipos de coronavirus del laboratorio de Wuhan lo habían ido a buscar allá, a tomar muestras a Yunnan y lo habían traído al laboratorio para poder estudiarlo, y lo habían descrito en 2013.
Entonces es legítimo preguntarse si esa fue la manera en que el virus salió de la gruta de Yunnan, para llegar hasta Wuhan, y luego para ser estudiado habría sido manipulado, cambiándole las secuencias para ser estudiando en células humanas.
Y, si acaso eso ha sido lo que ha generado este virus, que después, accidentalmente, porque no hay necesidad de complot sino por medidas de seguridad insufientes, alguien se ha contaminado y ha sacado el virus del laboratorio.
Eso sigue siendo una pregunta abierta, no se sabe.
Fuente de la imagen, Getty
¿Cuáles son las principales preguntas sobre el coronavirus que áun no tienen respuesta?
Son miles. Este es un principio, hay mucho que entender, hay casi todo que entender.
Por qué el coronavirus en mucha gente no tiene ningún efecto o síntoma, y por qué a otra gente la mata.
Ese es un punto central y mientras no se haya entendido eso, no vamos a entender esta enfermedad.
Hay pistas que sugieren que probablemente la respuesta rápida del sistema inmune al virus no se pone bien en marcha en ciertos individuos y eso hace que las etapas más tardías de la respuesta inmune no se regulen, y eso genera una inflamación masiva.
Pero eso es una pista, hay muchas otras.
Yo pienso que mucha de la particularidad de este virus viene del hecho de que no solo infecta al sistema respiratorio, sino también al sistema nervioso.
Hay gente que no desarrolla la enfermedad grave, pero tiene la enfermedad larga. ¿Eso de dónde viene? Claramente no viene de la infección de los pulmones, como se pensó inicialmente. ¿Puede venir de la infección del sistema nervioso?, ¿acaso persiste el virus en esa gente?, ¿qué pasa con la respuesta inmune de esa gente?
Hay miles de cosas por entender. No hemos entendido nada, la verdad.

Fuente de la imagen, Getty
Eso suena desalentador...
Lo que hay que decir es que tenemos una herramienta fabulosa para detener la pandemia, que son las vacunas. Sin embargo, por qué el virus tiene efectos casi inexistentes en ciertas personas y en otras los mata, no se entiende.
Y eso no es desalentador, todo lo contrario, tiene que alentar a los científicos. A nosotros nos interesa lo que no se entiende, no lo que se entiende.
Y así debería ser en la población, que cada uno se interese en lo que no se entiende.

Ahora puedes recibir notificaciones de BBC Mundo. Descarga la nueva versión de nuestra app y actívalas para no perderte nuestro mejor contenido.
Este artículo contiene contenido proporcionado por Google YouTube. Solicitamos tu permiso antes de que algo se cargue, ya que ese sitio puede estar usando cookies y otras tecnologías. Es posible que quieras leer política de cookies y política de privacidad de Google YouTube antes de aceptar. Para ver este contenido, selecciona 'aceptar y continuar'.
Fin del contenido de YouTube









